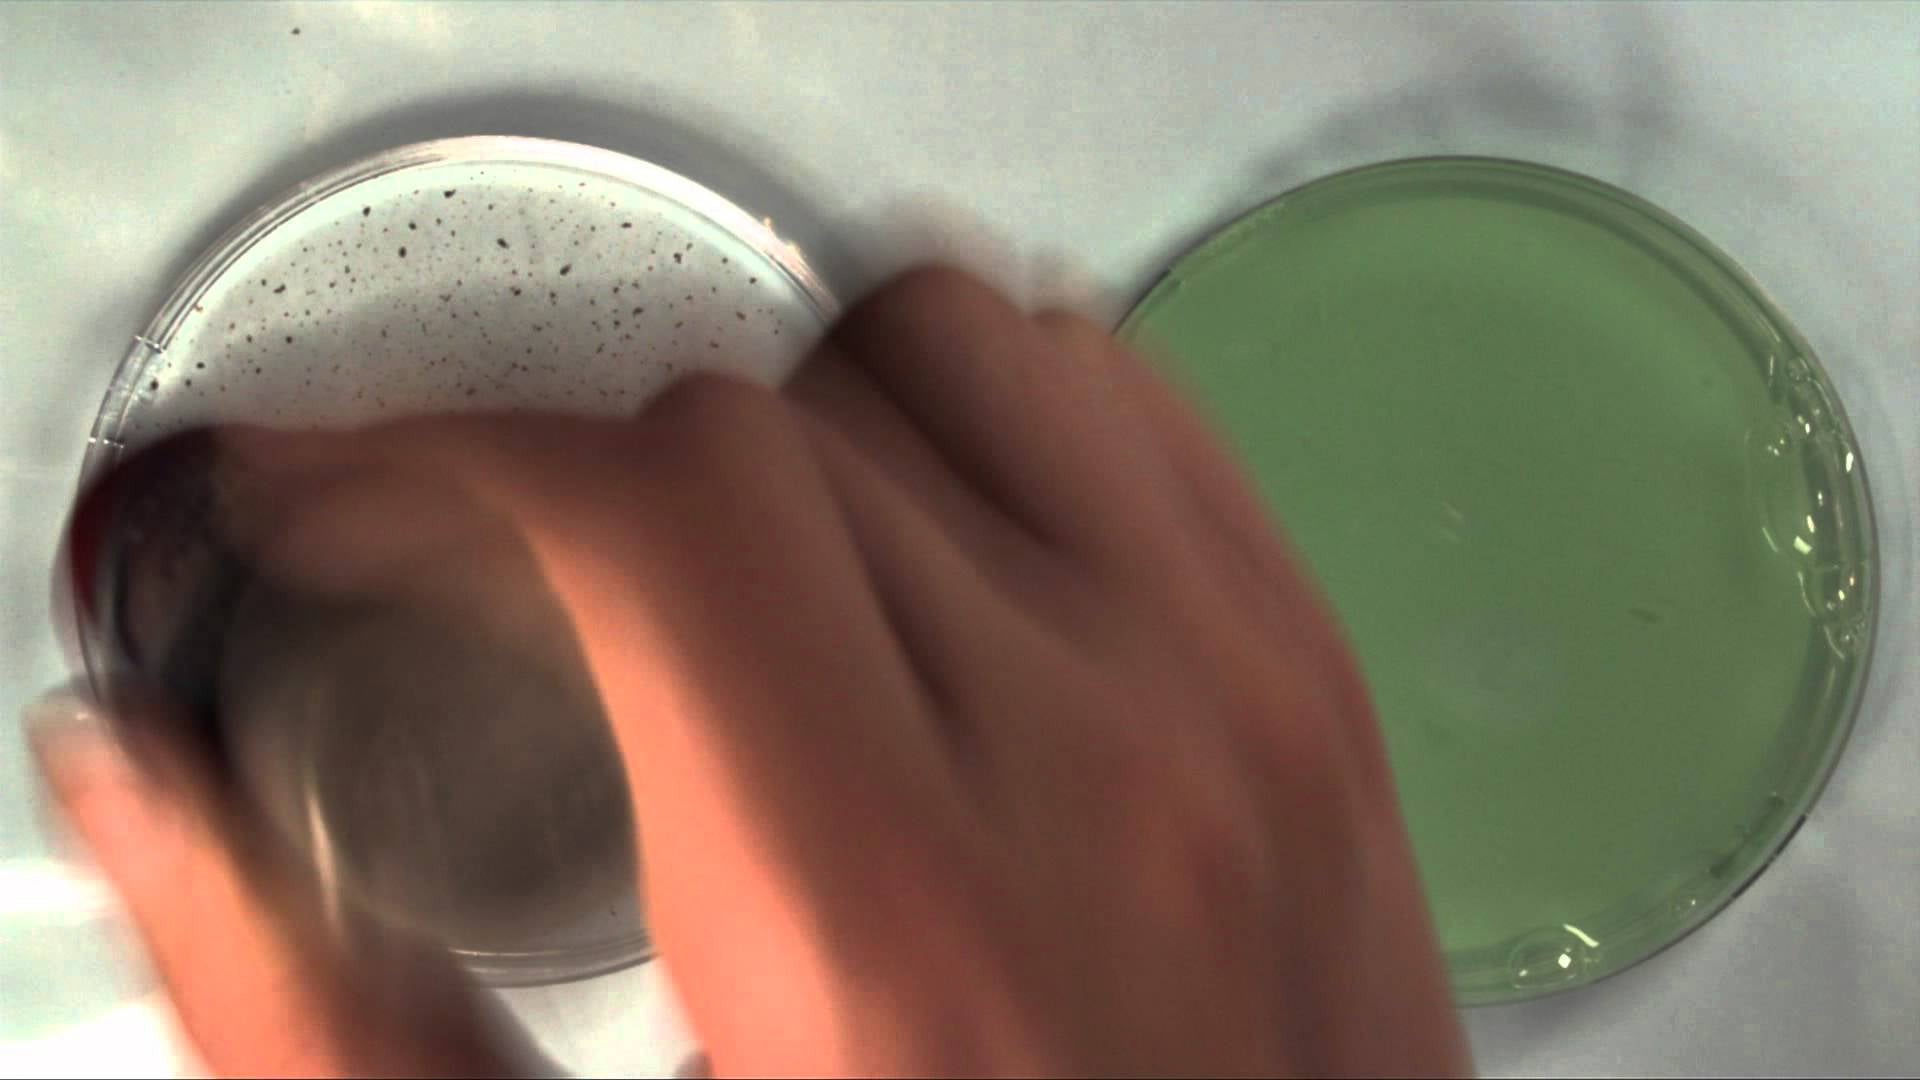

Yesterday we saw bugs using fluid dynamics to propel themselves around. It turns out that one scientist is turning that into a fun way to add alcohol to a drink. Here’s how to make a moving boat using the Marangoni Effect.
You can observe the Marangoni Effect very easily if you have a dish, a little water, a little pepper, and some dish soap handy. Pour a little water into the dish. Sprinkle the pepper over the water—it should rest on top of the water instead of sinking. Put a drop of dish soap in the palm of your hand. You might want to mix it with a little more water so it’s good and runny.
Collect just a drop of the soapy water on your finger, then place it in the center of the dish full of pepper-water. You should see all the pepper dash away to the very edge of the water, forming a kind of ring around a wide expanse of clear water.
What you’re seeing makes it look like the soap is “chasing away” the pepper. Actually, it’s more like the pepper is being dragged away by the non-soapy water. Imagine stretching a balloon out and covering it with dots and then taking a pin and popping the balloon.
Water molecules pull on each other—it’s a property called cohesion—and that pull is what forms the “skin” on the surface of water. Soap is a surfactant, a chemical that lessens the surface tension. When the soap is added to the water, it stops pulling. (Or at least it stops pulling as hard.) Meanwhile, the nonsoapy water is still pulling as hard as ever, and pulls the water, and the pepper resting on top of it, to the edges.
Some insects make use of surfactants. They release surfactant chemicals into the water, which allows the water behind them to give up its pull and the water in front of them to tug them forward. Researchers at MIT constructed a “cocktail boat” that would work on the same principle. The boats have a little well which is filled with alcohol. Alcohol has a lower surface tension than water. The more alcohol that is mixed with the water in any one part of a drink, the lower surface tension it will have, so as the “boat” lets alcohol leak out behind it, it scoots around the cocktail.
People have done this with liquid soap in water, but not with alcohol in slightly-less-pure alcohol. It looks like the researchers who came up with the idea are still looking for a market, so you can’t buy it yet, but if you want to tinker with the idea, you could probably make your own personal cocktail boat, for when you drink at home alone. Give it a try sometime.